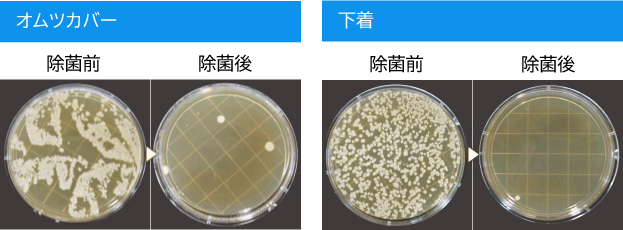

水が持っているチカラ
それは電解水。
アルカリ性電解水と酸性電解水が
パワーのヒミツ!
目には見えなくても、私たちが暮らす日常空間には様々な細菌が潜んでいます。 その対策として有効な手段が、塩と水を電気分解して生成する「電解水」。 洗浄力の「アルカリ性電解水」と除菌力の「酸性電解水」が、施設の衛生管理をサポートします。 しかも、生成には薬品類をいっさい使用しないため、安心してご使用いただけます。 食品業界や福祉施設をはじめ幅広いシーンで、清潔な環境作りをお手伝いいたします。
食中毒や施設内感染を防ぐために菌やウィルスを強力に除菌。

酸性電解水が食中毒の元になる大腸菌やサルモネラ菌、黄色ブドウ球菌、腸炎ビブリオ菌などを除菌します。
ノロウィルス対策にも。
施設のノロウィルス対策に『守る水』を活用いただけます。
ノロウィルスは細胞培養できないため、一般的な代替ウィルスであるネコカリシウィルスを使ってウィルス不活化試験を行い、有効なデータも得られています。
■試験依頼先:財団法人食品分析センター
高い除菌力
酸性電解力に含まれる次亜塩素酸が次亜塩素酸イオンよりも高い除菌効果を発揮します。
水なのに、驚異の洗浄力。
水のチカラで、ここまでキレイに!
2つのチカラ
洗浄力を越えたマルチなパワー。
これが「守る水」の実力。
除菌力
酸性電解水に含まれる次亜塩素酸が洗濯しながら除菌します。
電解水を洗濯水として使用した際の除菌効果

脱臭力
アルカリ性電解水で臭いの元や細菌の餌となるたんぱく質・油脂汚れを分解洗浄します。
その後、酸性電解水で様々な菌を除菌します。
洗浄&除菌。W効果の電解水。汚れの中に潜む菌も、効果的に除去します。

守る水の活用事例のご紹介
※洗浄後は水道水などで取り除いてください。
食の現場の設備環境衛生を
電解水の力でサポートする。
細菌やウイルスから身を守るには、「食品衛生7S(整理・整頓・清掃・洗浄・殺菌・しつけ・清潔)」を踏まえ、 環境衛生についての徹底した施策が重要です。
これをサポートするのが電解水の洗浄・除菌効果。調理場・調理器具から、食材・食品の保管スペースまで。食にまつわる衛生管理に、電解水が活躍します。

食品売場に
フロアから陳列棚まで。電解水を使用すれば隅々まで除菌できます。

キッチンまわりに
アルカリ性電解水でたんぱく質汚れを落とし、酸性電解水で除菌と消臭を行います。

床・排水溝の洗浄に
効率的な清掃作業に欠かせない電解水。泡立つことなく洗浄、除菌できる使い勝手の良さがあります。

お客さま用カートにも
たくさんの人が触れる物にこそ安心を。皮脂汚れ等を分解しながら、除菌力を発揮します。
「安全・安心」な水
「水」「塩」「電気」から生成される電解水。私たちが普段の生活でよく使うものを原料として「除菌水」や「洗浄水」が作られます。 「安全・安心」な原料から生まれる「安全・安心」な環境を「守る水」。この水を作り出す「マルチセル型電解槽」には、多くのノウハウと可能性がつまっています。
増え続ける介護サービス施設。およそ15万事業所。
施設の総合的な衛生管理を電解水で。
高齢者施設においては高いレベルの衛生管理が求められます。そこで、電解水。衣類やシーツの洗濯をはじめ、調理器具や食器、介護用具まで、生活空間としての施設全体を電解水の衛生力がカバーするので高齢者施設でも安心して使用できます。

洗濯水に
洗浄力のアルカリ性電解水。除菌力の酸性電解水。電解水のW効果は洗濯に最適です。

拭き掃除に
洗浄のアルカリ性電解水と除菌の酸性電解水。混ぜて使用しても安全です。洗浄・除菌を続けて行っても安心してご使用になれます。

食器・調理器具に
清潔な調理環境のために。しつこい汚れの分解には漬け置きが効果的です。※2:金属・ゴム・樹脂製の食品類は変色等がある場合がございます。

清掃用具にも
バケツ等に貯めたアルカリ性電解水と酸性電解水でモップをゆすり洗い。除菌と消臭が行えます。
年間5億3,800万人が利用する国内の宿泊施設。
求められるのは質の高い衛生管理。
オフィスビル、ホテル、商業施設、駅。不特定多数の人が集うパブリックスペースにおいては、往来する人数の増加に比例して菌との接触確率も必然的に高まります。 現実的な対策として有効なのが、その空間を最大限「清潔」に保つこと。その要求に電解水の洗浄・除菌効果が応えます。管理する場所が多ければ多いほど、電解水が役立ちます。

ホテルの客室に
客室内を効果的に洗浄と除菌。消臭効果でお部屋の臭いもすっきり。

トイレに
「裏の玄関」とも呼ばれる場所だからこそ、一番清潔に。汚れも菌も臭いも電解水で一括除去。

ビルメンテナンスに
効率的な清掃作業に欠かせない電解水。泡立つことなく洗浄、除菌できる使い勝手の良さがあります。

商業施設に
エスカレーター、吊革、ドアノブ等、不特定多数の人が接触する箇所も拭くだけで簡単除菌。
「普段使い」ができる
生成された電解水は、特殊な薬品などを加える必要もなく、そのまま使用できます。幅広く、様々な器具と組み合わせて日常的な清掃作業に対応。 「普段使い」できる。この使い勝手のよさが特長です。
年間700万t以上の乳製品が日本国内で生産。
徹底した衛生管理で「安心」を食卓へ。
細菌やウイルスから身を守るには、「食品衛生7S(整理・整頓・清掃・洗浄・殺菌・しつけ・清潔)」を踏まえ、 環境衛生についての徹底した施策が重要です。
これをサポートするのが電解水の洗浄・除菌効果。調理場・調理器具から、食材・食品の保管スペースまで。食にまつわる衛生管理に、電解水が活躍します。

長靴の洗浄・除菌に
泥汚れなどの洗浄や内部の消臭に。また出入口での靴底の除菌用水として。

作業器具に
毎日使用する器具・用具の洗浄に。搾乳器など、家畜に触れる器具もくまなく除菌します。

畜舎に
残留性が少ないため、畜舎の清掃にも使用可能。除菌・消臭で健やかな生育をサポートします。

運搬車両の洗浄にも
運搬用トラックの荷台・保冷庫などの除菌にも効果を発揮します。
農薬と菌から消費者を守るために
生鮮野菜の輸入量はこの20年間で4倍と大幅に増加しました。 しかしその反面、海外の生鮮野菜に関連する産品の安全性に関して消費者の懸念が高まってきているのもまた事実であり、国産生鮮野菜への回帰指向が強まっています。 国内の産地に寄せられた信頼を維持・向上させるためにも、安全対策は必須条件。 収穫用器具や運搬用器具、流通用のトラックなど、収穫物の周辺環境に使用することでさらなる安全を確保することができます。
温浴施設の天敵ともいえるカビ、雑菌。
快適な環境をお客様に提供するために。
カビや雑菌は循環式浴槽、冷却塔など、温かく栄養分のある水が循環している設備の中において非常に高い繁殖率を示します。 これらの設備ではバイオフィルム(いわゆる「ぬめり」)が発生しやすく、カビや雑菌はこのバイオフィルムに生息するアメーバに寄生して増殖するためです。 このカビや雑菌対策に有効なのが、電解水。まず、アルカリ性電解水が菌の温床となるぬめりを洗浄。 続いて、酸性電解水で菌そのものを除去。浴場から送水用配管まで、幅広く使用できます。

浴場全体に
カビ等が発生しやすい床、浴槽、椅子、タイルの目地を電解水で洗浄・除菌します。

サウナに
素肌が触れるサウナの座面。普段の清掃における電解水利用で、さまざまな菌を除菌します。

岩盤浴に
岩盤の表面の菌を拭き取り、除菌と消臭を同時に行います。

タオル・衣類にも
菌が付着しやすいタオルや足拭きマット。電解水を使用した洗濯でしっかりと除菌。
コストに強い、環境にやさしい
洗浄効果を有するアルカリ性電解水。この効果により、通常と比べて少ない洗剤量で洗濯を行うことができます。 また、洗剤量が抑制されるため、すすぎ行程が短縮。水道代が軽減されます。 さらに、電解水は常温でも洗浄効果を十分に発揮するため温水生成のためのボイラー燃料代も軽減。 さまざまな面からコストカットのお手伝いをします。 一方、環境面についても、電解水そのものは薬品を含まず、洗剤や使用水量の削減から、環境にやさしい水として、企業・団体における国際環境基準ISO14001の運用をサポートします。